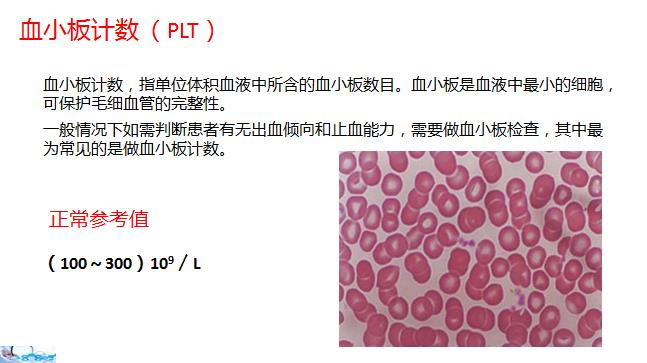

一分钟教你读懂体检报告单(血常规)
一分钟教你读懂体检报告单(血常规)
血常规,就是全血细胞(白细胞、红细胞和血小板)的计数(英文:complete blood count,CBC; full blood count,FBC)。计数结果的异常(增高或降低)可能表示存在多种疾病,可作为病人身体健康状况的参考,属于医学领域中最为常见的血液检验项目之一。血常规的检测主要包含:血红蛋白(Hb)、红细胞比积(PCV )、红细胞计数 (RBC )、红细胞平均体积( MCV )、红细胞平均血红蛋白量(MCH)、红细胞平均血红蛋白浓度(MCHC)、白细胞计数 (WBC )、血小板计数 (PLT)等。

血红蛋白降低(俗称贫血)一般提示人体摄入的铁、维生素B12、叶酸等营养素不足,此外,严重蛋白质能量营养不良时,血红蛋白也明显降低。


比积降低见于各种贫血、癌症及稀血症;增加见于脱水、急性心肌梗死及红细胞增多症。此外,在纠正脱水及电解质平衡失调时,常需测红细胞比积作参考。

临床意义同血红蛋白测定,部分贫血患者,同时测定二者,对贫血诊断和鉴别诊断有帮助。

-
- 寻仙手游探索任务攻略 探索任务攻略大全
-
2025-03-15 02:25:33
-

- 新车 - 售价9.19万元起,黄海全系皮卡上市,采用“龙”系列新命名
-
2025-03-15 02:23:18
-

- 推荐5篇完结小说,种田文,穿越时空,随身空间,励志人生
-
2025-03-15 02:21:03
-

- 孙世林再次亮出成名绝技“世林赞” 却得到广大球迷叫好鼓掌
-
2025-03-15 02:18:48
-

- 双7nm芯片,提前进入5G时代,一个简单的华为Mate20X5G开箱
-
2025-03-15 02:16:33
-

- 石楠:抗有毒气体能力强,有镇静解热等作用
-
2025-03-15 02:14:18
-

- 榴莲芝士饼制作方法
-
2025-03-15 02:12:03
-

- 夸克联盟涉嫌非法经营保险业务 网上互助保障的无牌尴尬
-
2025-03-15 02:09:48
-

- 这10个副业兼职,在家也能赚点儿零花钱~
-
2025-03-14 09:32:34
-

- 扬州周边游:润扬森林公园,马可波罗花世界,隋炀帝陵,普哈丁园
-
2025-03-14 09:30:19
-

- 幸福250摩托车原来是自行车厂生产的!当年骑着你觉得幸福吗?
-
2025-03-14 09:28:04
-
- 他侵害3名20岁女大学生,却被无罪释放,全因体内居住着24个人格
-
2025-03-14 09:25:48
-

- 十年了!苏巴西奇用这样的方式纪念离世的挚友
-
2025-03-14 09:23:33
-

- 旧金山机场成网友最爱“晒”全美十大机场之一
-
2025-03-14 09:21:18
-

- 火影忍者回忆录,人物之海野伊鲁卡
-
2025-03-14 09:19:03
-

- K1302次列车运行线路图:内蒙古满洲里开往北京,全程1577公里
-
2025-03-14 09:16:48
-

- 2月1日大事记
-
2025-03-14 09:14:33
-

- 以假乱真的纸藤满天星折纸图解教程
-
2025-03-14 09:12:18
-
- 欧洲古董油画:19世纪末英国画家梅纳德手绘肖像画《新娘》
-
2025-03-14 09:10:03
-

- 乐高星球大战75354科洛桑卫队炮艇正式亮相
-
2025-03-14 09:07:48



 妻子五年出轨500多次!丈夫愤怒曝光聊天记录,震撼揭露背后真相
妻子五年出轨500多次!丈夫愤怒曝光聊天记录,震撼揭露背后真相 杖责系列-为了立规矩、嫔妃挨屁股板子,嬷嬷使坏、主子遭遇难堪
杖责系列-为了立规矩、嫔妃挨屁股板子,嬷嬷使坏、主子遭遇难堪